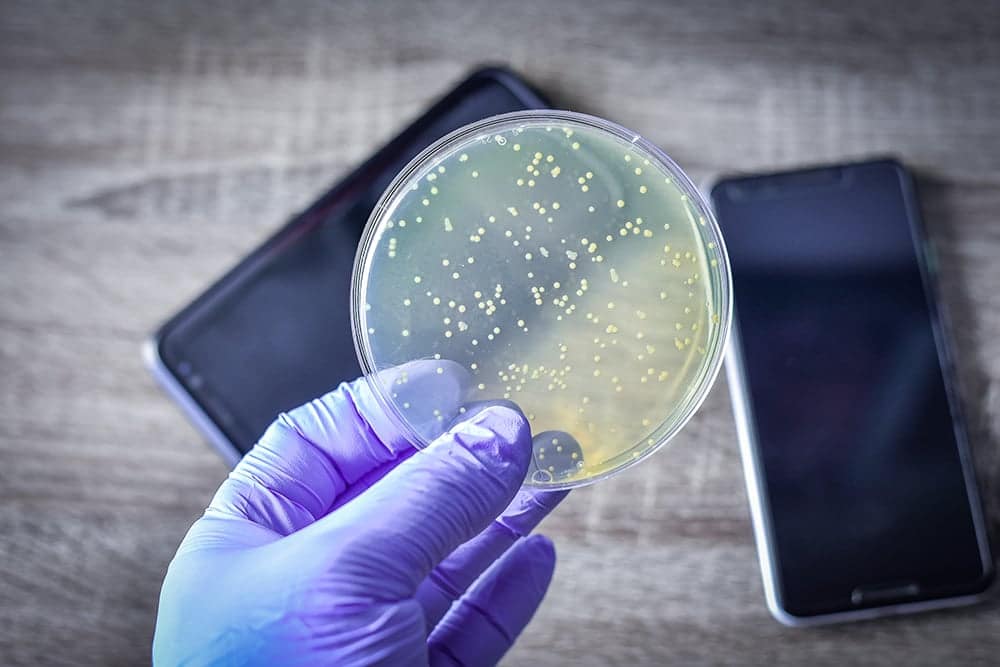
Eng ko‘p mikrob to‘planadigan buyumlar qaysi

Kundalik hayotda tez-tez ishlatiladigan ayrim buyumlar eng ko‘p mikroblar to‘planadigan joy hisoblanadi. Sanepidqo‘mitaga ko‘ra, eng iflos besh buyum qatoriga telefon ekrani, oshxona gubkasi, muzlatkich tutqichi, pul va bank kartalari hamda bolalar o‘yinchoqlari kiradi.
Shifokorlar ogohlantirishicha, aynan shu buyumlar orqali ichak infeksiyalari, teri kasalliklari va nafas yo‘llari infeksiyalari yuqishi mumkin.
Oddiy gigiyena qoidalariga rioya qilish orqali xavfni kamaytirish mumkin. Telefonni kuniga kamida bir marta artib turish, oshxona gubkasini 5–7 kunda almashtirish, bolalar buyumlarini muntazam yuvish va ovqatdan oldin qo‘l yuvishni odat qilish tavsiya etiladi.
Mutaxassislar ta’kidlashicha, kasalliklarning 70 foizi oddiy gigiyena qoidalariga amal qilinmagani sababli kelib chiqadi.
Eslatib o‘tamiz, avvalroq Yevropaning 29 ta davlatida chikungunya virusi tarqalish xavfi yuzaga kelgani haqida xabar berilgandi. Chikungunya virusi insonlarda kuchli holsizlik va bo‘g‘imlarda azobli og‘riqni keltirib chiqaradi. Bu kasallik, ayniqsa, bolalar va keksalar uchun o‘lim xavfini tug‘dirishi mumkin. Ma’lumotlarga ko‘ra, bemorlarning 40 foizi tuzalganidan so‘ng ham besh yil davomida artritdan aziyat chekadi.